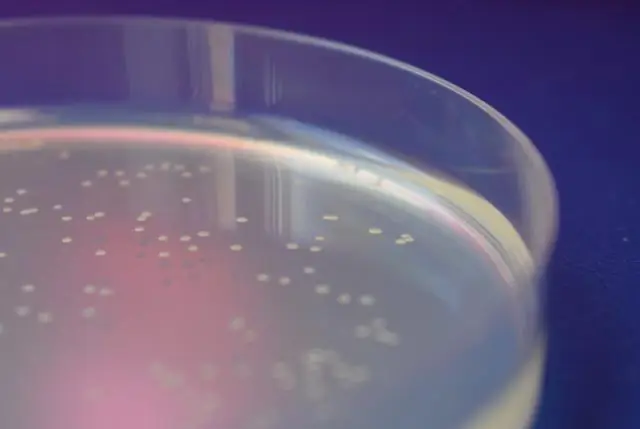
Использование кишечной палочки для создания биопродуктов, таких как биодизель, экономически эффективным способом

Кто знал, что потенциально смертельные бактерии можно использовать во благо?
Аспирант машиностроения ЛГУ Татьяна Мелло из Пирасикабы, Бразилия, в настоящее время работает над генной инженерией и оптимизацией бактерий кишечной палочки для производства биопродуктов, таких как биодизель, экономически эффективным способом. Это предприятие привлекло внимание многих специалистов в области инженерии и биологии, а также дало ей возможность рассказать о своих исследованиях на недавней Национальной конференции и выставке по биодизелю в Сан-Диего.
Мелло предлагает использовать бактерии кишечной палочки для расширения производства биодизеля за счет создания нового вида сырья.
«Основным сырьем, используемым в США для производства биодизеля, являются соевое и кукурузное масло», - сказала она. «Фактического производства достаточно, чтобы прокормить нас, но у вас есть излишки, с которыми никто не знал, что делать, поэтому было создано биодизельное топливо. Этот рынок растет и растет. Они ожидают, что через несколько десятилетий излишков не хватит, чтобы производить биодизель. E. coli дешева и широко распространена, и вы можете просто генетически модифицировать ее, чтобы удовлетворить эту потребность».
Главной целью Mello является создание биопродуктов малонил-КоА, таких как биодизель, пластмассы, полимеры и фармацевтические препараты. Малонил-КоА обнаружен в бактериях человека и играет важную роль в регулировании метаболизма жирных кислот и приеме пищи; это также привлекательная цель для открытия новых лекарств.
"Максимизация малонил-КоА является темой моего исследования, потому что это предшественник очень многих вещей", сказала она.
Мелло, которая работала над этим проектом в течение двух лет, имела честь представить свой проект на Национальной конференции по биодизелю и выставке в Сан-Диего в прошлом месяце. Только 12 специалистов университетского уровня в стране, которые заинтересованы в изучении биодизельной промышленности, получают стипендии для участия в поездках. Однако только четырем из этих студентов предлагается представить свои исследования.
Мелло сделала это в рамках организации «Ученые нового поколения для биодизеля», членом которой она является. Она сказала, что участие в конференции повлияло не только на ее карьеру и исследования, но и на ее понимание индустрии биодизеля.
«Я открылась для нового мира после того, как было развеяно заблуждение о пищевой промышленности и биотопливной промышленности, конкурирующей за пахотные земли», - сказала она. «Множество новых концепций, правил и вопросов, представленных во время быстро развивающегося мероприятия, намного лучше подготовили меня ко всему биодизельному бизнесу».
После получения степени бакалавра биологических наук в Университете Кампинас (Unicamp) в Сан-Паулу Мелло решила, что ей нужна еще одна степень, чтобы применить свои научные знания.
"Сначала я увлеклась биологией, потому что я была полностью посвящена изучению жизни", - сказала она. «Меня это очаровало. Когда я заканчивал биологию, я понял, что ничего не могу применить к тому, что изучаю. Это были инженеры. Мне нужны были биореакторы и оборудование. Поэтому я решил получить степень инженера».
Мелло осталась в Unicamp, где получила степень магистра медицины, а затем начала работать в Caterpillar Inc. в Бразилии.
"Находясь там, я понял, что хочу совместить две степени бакалавра", - сказал Мелло.
Она связалась с профессором МЭ ЛГУ Марсио де Кейросом, который также из Бразилии и сейчас служит ее советником. У нее также есть соконсультанты, такие как профессор биологических наук ЛГУ Гровер Уолдроп, и она говорит, что все они работают вместе и подали патент на ее проект.
Мелло собирается окончить LSU в мае и планирует остаться на юго-востоке Луизианы, надеясь найти работу в районе Батон-Руж. Конечно, все зависит от того, какая компания будет открыта для ее новой идеи.
«У нас есть этот метод, и он работает, но нам нужны отраслевые партнеры, чтобы масштабировать его», - сказала она.